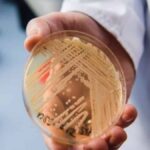
ψανδιδα

Η σχετική ανάρτησή της μητέρας, απέσπασε ένα like από την μπάντα.
Μία γυναίκα στην Βραζιλία έφερε στον κόσμο το μωρό της κατά τη διάρκεια συναυλίας των Metallica, το βράδυ του Σαββάτου.
Η μπάντα έπαιζε στο στάδιο Couto Pereira, στην πόλη Curitiba, στο πλαίσιο της περιοδείας τους στην Νότια Αμερική, που είχε αναβληθεί λόγω κοροναϊού.
Η tattoo artist Joice M Figueiró βρισκόταν στην 39η εβδομάδας της εγκυμοσύνης και πίστευε ότι είχε μπροστά της λίγες ημέρες ακόμα. Αποφάσισε να πάει να δει τη συναυλία όμως το μωρό είχε άλλη γνώμη!
Την ώρα που οι Metallica βρίσκονταν στη σκηνή, ξεκίνησαν οι συσπάσεις και έσπασαν τα νερά της. Καθώς δεν υπήρχε χρόνος ώστε να προλάβει να φτάσει στο μαιευτήριο, γιατροί που βρίσκονταν εκεί την μετέφεραν στην κλινική που είχε στηθεί για λόγους ασφαλείας στην χώρο της συναυλίας.
Το αγοράκι γεννήθηκε την ώρα που το συγκρότημα έπαιζε το Enter Sandman στις 23.15 το βράδυ τοπική ώρα.
«Ξεπέρασα τον εαυτό μου»
«Σε κάθε συναυλία που πηγαίνω πάντα κάτι συμβαίνει, αλλά αυτή τη φορά νομίζω ότι ξεπέρασα τον εαυτό μου» έγραψε στο instagram η μητέρα και ενημέρωσε ότι το μωρό είναι πολύ καλά στην υγεία του! Η γυναίκα λέει μάλιστα ότι το εισιτήριο για τη συναυλία των Metallica το είχε αγοράσει τρία χρόνια πριν, αλλά τότε είχε ακυρωθεί.
«Πότε δεν είχα φανταστεί ότι θα ήμουν σε μία συναυλία των Metallica στις 39 εβδομάδες κύησης και αυτό το αγοράκι θα αποφάσιζε να γεννηθεί ακριβώς εκεί, τρία μόλις κομμάτια πριν το τέλος της συναυλίας στο Couto Pereira και υπό τους ήχους του «Enter Sandman» έγραψε.
Όπως ήταν φυσικό η ανάρτησή της απέσπασε ένα like από την μπάντα.
πηγη-in.gr

Σημείωση: Τα σχόλια που εμφανίζονται κάτω από τα άρθρα αποτελούν προσωπικές απόψεις των χρηστών που τα δημοσίευσαν και δεν εκφράζουν απαραίτητα τις θέσεις ή απόψεις του Lamianow.gr.
Σε ορισμένες περιπτώσεις, σχόλια που έχουν διατυπωθεί δημόσια σε κοινωνικά δίκτυα ενδέχεται να εμφανίζονται κάτω από τα άρθρα, όταν έχουν δημοσιευθεί κάτω από σχετικές αναρτήσεις του ίδιου άρθρου. Το Lamianow.gr δεν φέρει ευθύνη για το περιεχόμενο αυτών των σχολίων.
Αν κάποιο σχόλιο θεωρείτε ότι παραβιάζει δικαιώματα, είναι προσβλητικό ή έχει αποσυρθεί από την αρχική του πηγή, μπορείτε να επικοινωνήσετε μαζί μας στο [email protected] για την άμεση αφαίρεσή του.